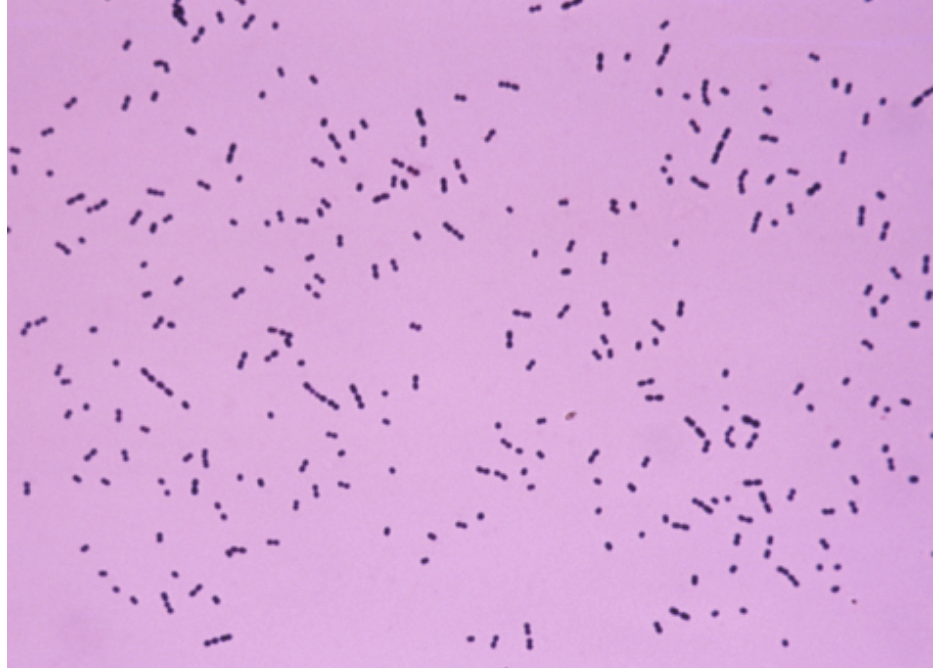

What is the most common organism to cause of CAP?
30-50% are Step pneumoniae
H.influenzae also common
Gram +ve (diplo Cocci)
What is typical culture appreance of Strep pneumoniae?
Gram+ve diplocicci
+ve alpha haemolytic (greenish tinge)
Optochin sensitive: bacteria will not grow in the presence of optochin

What is the antibiotic of choice for Pneumococcal pneumonia?
Always always penicillin sensitive –>
1st line with low severity: Amoxicillin (works well against mos typical CAP)
2nd line in higher severity pneumonia: Co-amoxiclav + Erythromycin/ Clarythromycin

What is pneumonia?
Inflammation of the lung alveoli
Other Strep pneumonia, what other organisms commonly cause CAP?
What are the population characteristics of each?
- Haemophilus influenzae (Smoking/ COPD)
- Staph Aureus (recent viral infection, e.g. influenza)
- Moraxella catarrhalis (Associatec with smoking, Gram -ve cocci)
- Klebsiella pneumoniae (in alcoholics, elderly - cause for haemoptysis)
What is the most common pathogen to cause pneumonia in neonates (1monts)
E.coli
GBS
Listeria
What criteria are included in the CURB-65 score?
- Confusion
- Urea >7
- RR >30
- BP <90 systolic <60diastolic
- > 65
What is bronchitis?
Inflammation of medium sized airways
What are risk factors in development of bronchitis?
Smoking
What are the common pathogens causing bronchitis
Usually viral
But also similar organisms as Pneumonia (Pneumococcus and H.influenzae)
What are characteristics of a H.influenzae pneumonia?
- more common in pre-existing lung disease
- Risk Factors: smoking/ COPD
- can be cavetating
What is the microscopical appearanche of H.influenzae?
Gram -ve coccibacilli

What is the antibiotic of choice for treatment of H.influenzae?
Can produce ß-lactamases
(Generally for all CAP: Amoxicillin/ Co-amoxicalv if ß-lactamase)

What is a commmon presentation/ history for a Legionella pneumonia?
Exposure to Air conditioning/ Travel
and/or Water fountain
Other features
* confusion, abdo pain, diarrhoea
* lymphopenia, hyponataemia
What investigations should be sent in a suspected legionella pneumonia?
Urinary or serum Legionella antigens
(If travel histroy might not detect all legionella species)
What features could suggest an atypical pneumonia?
What ABX would you choose?
Flu-like prodrome before fever
Extrapulmonary features, such as:
* hepatitis
* hyponatremia
Mainly clues in history
Macrolides (clarythor/erythro)
Tetracyclines (Doxy)
What is the abx choice for a Legionella pneumonia?
Sensitive to Macrolides
What is an empyema?
Pulmonary abscess
What are risk factors for the development of an empyema?
- Resistant organism
- Proximal obstruction (tumour)
- not recieving/ absorbing ABx
- Immunosuppression
- Other underlying lung disease
What are common causes of pneumonia in 1-6 months olds?
Chlamydia trachomatis
S.aureus
RSV
What is the most common cause of pneumonia in 6 months - 5year olds?
Mycoplasma
Influenza
What are the most common pathogens to cause pneumonia in 16-30 year olds?
M.pneumoniae
S. pneumoniae
What are characteristics of PCP/ Pneumocystic jiroveci penumonia?
Usually
* insidious onset
* dry cough, weight loss, SOB, malaise
* On CXR: bat’s wing (bilateral
* Walk test: decrease on exhaustion
Protozoa causing pneumonia
What are the most common pathogens causing a HAP?
Usually Gram -ve organisms (as often gram+ve abx coverage given in hospitals)
*








